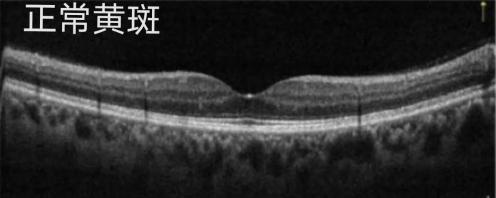

激光笔伤眼现状
激光笔在教育与娱乐行业中普遍使用,市面上许多产品的功率较高且价格适中。许多孩子将其作为玩具,但并未充分意识到激光笔可能引发的风险,对潜在的危害缺乏足够的重视。眼科专家孙雯主任表示,每年都有不少儿童因激光笔直接照射而遭受视力损伤,这一情况令人遗憾。
研究结果表明,儿童因认知能力有限且好奇心旺盛,对激光笔表现出强烈的兴趣。在游戏时,他们往往忽视安全措施,对激光笔可能导致的严重伤害认识不够,因此激光笔对儿童视力存在潜在风险。
亮亮的不幸遭遇
近期,亮亮的母亲感到极度忧虑,急忙带孩子赶往眼科急诊。该情况起因于亮亮前一天在与朋友玩耍时,出于好奇,他使用激光笔对右眼进行了短暂的照射。起初,亮亮以为只是被强光闪了一下,稍作休息便可恢复,然而,经过一整天,他的视力并未恢复到原先水平。
检查结果显示,亮亮的黄斑区结构遭受了严重损害。他的右眼视力已无法恢复至正常水平。无论是药物治疗还是手术治疗,均未能达到预期效果。这一案例突显了激光笔对儿童视力可能造成的严重危害。其后果之严重令人深感痛惜。同时,这一情况也对众多家长提出了警示。

激光笔的可怕危害
激光笔虽给人以安全之感,然而其聚焦后的亮度远超太阳表面,甚至可达到千万倍之高。此外,激光具备光热、光电离及光化学等多种效应,任何一种都可能对眼睛造成伤害。
特别值得关注的是,视锥细胞在人体内的再生能力极为有限。一旦遭受激光伤害,这种损伤通常难以修复,有可能转变为永久性伤害。因此,儿童的视力可能会遭受严重损害,这种影响甚至可能持续一生,显著降低他们的生活质量。
医生的特别提醒
孙雯主任强调,家长需向孩子明确激光笔非玩具属性,并严格禁止孩子直视激光。在日常生活里,需将工作或教学用激光笔存放在儿童无法触及的安全区域,以防误操作发生。
家长需教育子女识别潜在风险并提升安全意识,警示他们避免直视过强的耀眼光线,并严格禁止使用激光照射他人,以减少意外伤害的风险。唯有从源头着手,预防措施得当,方能最大限度地确保孩子的视觉安全。
伤眼后的正确处理
一旦发现激光对眼睛造成伤害,应立即闭上眼睛并迅速转动头部以减少不适,同时切勿用力揉擦。必须立刻寻求专业医疗援助,摒弃任何侥幸心理,力争在伤害恶化前得到及时治疗。治疗延误可能会引发更严重的后果。
针对此类状况,许多家长常感困惑,并采取了错误的做法,比如揉擦眼睛,这种行为可能会加剧眼部伤害。鉴于此,推广正确的处理方法显得尤为迫切。

先进设备守护眼健康
医疗机构致力于增强儿童视力保护效能,引入了尖端技术设备。欧堡超广角眼底成像技术仅需0.25秒即可完成200°的视网膜扫描。该技术无需散瞳,即可获取超过82%的视网膜图像。特别适用于那些难以进行散瞳的患者和儿童。

Humphrey视野分析仪能准确辨别视野缺失的信号,并通过趣味性测试来完成这一过程。该设备具备全面的诊断功能,包括定性、定位和定量分析。三款设备均具有非侵入性、快速且精准的检查特性。这些特性显著减轻了儿童的检查不适和哭闹,有助于医生在早期阶段发现眼部疾病。这一措施对于保障儿童的视力健康具有重要意义。
若孩子出现视力模糊、频繁眨眼等状况,家长需予以关注,并迅速带其至权威眼科机构进行检查。激光笔可能对儿童视力造成不良影响,对此现象您有何见解?欢迎在评论区留言,并请对本文给予点赞与转发支持。